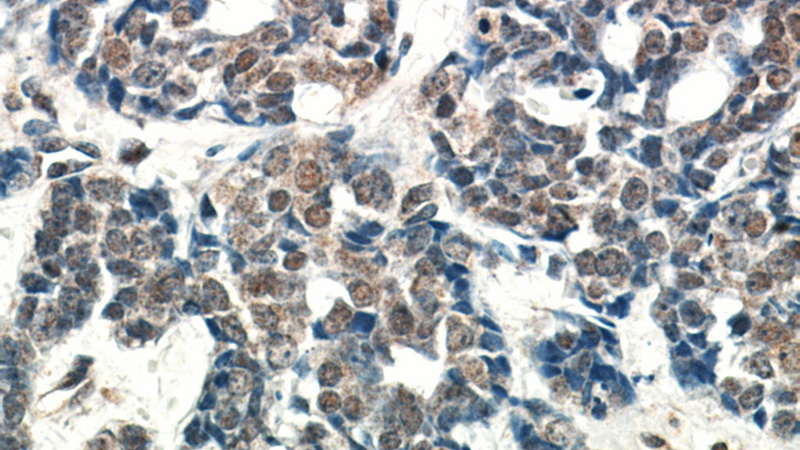
Immunohistochemical of paraffin-embedded human cervical cancer using Catalog No:107948(AKT antibody) at dilution of 1:50 (under 40x lens)

-
Product Name
AKT1 antibody
- Documents
-
Description
AKT1 Rabbit Polyclonal antibody. Positive WB detected in HeLa cells, A549, A549 cells, HepG2 cells, human liver tissue, mouse testis tissue, siRNA cells. Positive IP detected in HeLa cells. Positive FC detected in HeLa cells. Positive IHC detected in human cervical cancer tissue, human breast cancer tissue, human ovary tumor tissue. Positive IF detected in HeLa cells. Observed molecular weight by Western-blot: 62 kDa
-
Tested applications
ELISA, WB, IHC, IP, FC, IF
-
Species reactivity
Human,Mouse,Rat,Zebrafish; other species not tested.
-
Alternative names
AKT antibody; AKT1 antibody; PKB antibody; PKB ALPHA antibody; PRKBA antibody; Protein kinase B antibody; Proto oncogene c Akt antibody; RAC antibody; RAC ALPHA antibody; RAC PK alpha antibody
-
Isotype
Rabbit IgG
-
Preparation
This antibody was obtained by immunization of AKT1 recombinant protein (Accession Number: NM_001382430). Purification method: Antigen affinity purified.
-
Clonality
Polyclonal
-
Formulation
PBS with 0.02% sodium azide and 50% glycerol pH 7.3.
-
Storage instructions
Store at -20℃. DO NOT ALIQUOT
-
Applications
Recommended Dilution:
WB: 1:200-1:2000
IP: 1:200-1:2000
IHC: 1:20-1:200
IF: 1:50-1:500
-
Validations

siRNA AKT1 result from Dr. Eva Martinez-Balibrea. Green:tubulin, Red:Catalog No:107948, AKT1.

HeLa cells were subjected to SDS PAGE followed by western blot with Catalog No:107948(AKT antibody) at dilution of 1:500

IP Result of anti-AKT (IP:Catalog No:107948, 3ug; Detection:Catalog No:107948 1:500) with HeLa cells lysate 2500ug.

Immunohistochemical of paraffin-embedded human cervical cancer using Catalog No:107948(AKT antibody) at dilution of 1:50 (under 10x lens)
Immunohistochemical of paraffin-embedded human cervical cancer using Catalog No:107948(AKT antibody) at dilution of 1:50 (under 40x lens)

Control:siRNA AKT1 result with Pan-AKT antibody.From Dr.Eva Martinez-Balibrea.

Immunofluorescent analysis of (10% Formaldehyde) fixed HeLa cells using Catalog No:107948(AKT Antibody) at dilution of 1:50 and Alexa Fluor 488-congugated AffiniPure Goat Anti-Rabbit IgG(H+L)

1X10^6 HeLa cells were stained with 0.2ug AKT antibody (Catalog No:107948, red) and control antibody (blue). Fixed with 90% MeOH blocked with 3% BSA (30 min). Alexa Fluor 488-congugated AffiniPure Goat Anti-Rabbit IgG(H+L) with dilution 1:1000.
-
Background
The serine-threonine protein kinase AKT1 is catalytically inactive in serum-starved primary and immortalized fibroblasts. AKT1 and the related AKT2 are activated by platelet-derived growth factor. The activation is rapid and specific, and it is abrogated by mutations in the pleckstrin homology domain of AKT1. It was shown that the activation occurs through phosphatidylinositol 3-kinase. In the developing nervous system AKT is a critical mediator of growth factor-induced neuronal survival. Survival factors can suppress apoptosis in a transcription-independent manner by activating the serine/threonine kinase AKT1, which then phosphorylates and inactivates components of the apoptotic machinery.
-
References
- Gong K, Li W. Shikonin, a Chinese plant-derived naphthoquinone, induces apoptosis in hepatocellular carcinoma cells through reactive oxygen species: A potential new treatment for hepatocellular carcinoma. Free radical biology & medicine. 51(12):2259-71. 2011.
- Nakhaei-Nejad M, Haddad G, Zhang QX, Murray AG. Facio-genital dysplasia-5 regulates matrix adhesion and survival of human endothelial cells. Arteriosclerosis, thrombosis, and vascular biology. 32(11):2694-701. 2012.
- Xu MF, Zhou H, Hu CY, Liang YQ, Hu L, Chen D. The mechanisms of EGFR in the regulation of axon regeneration. Cell biochemistry and function. 32(1):101-5. 2014.
- Liang YC, Wu HG, Xue HJ. Effects of PI3K inhibitor NVP-BKM120 on acquired resistance to gefitinib of human lung adenocarcinoma H1975 cells. Journal of Huazhong University of Science and Technology. Medical sciences = Hua zhong ke ji da xue xue bao. Yi xue Ying De wen ban = Huazhong keji daxue xuebao. Yixue Yingdewen ban. 33(6):845-51. 2013.
- Wang N, Zhang Y, Wu L. Puerarin protected the brain from cerebral ischemia injury via astrocyte apoptosis inhibition. Neuropharmacology. 79:282-9. 2014.
- Liu F, You X, Wang Y. The oncoprotein HBXIP enhances angiogenesis and growth of breast cancer through modulating FGF8 and VEGF. Carcinogenesis. 35(5):1144-53. 2014.
- Li J, Chen Y, Wan J, Liu X, Yu C, Li W. ABT-263 enhances sorafenib-induced apoptosis associated with Akt activity and the expression of Bax and p21((CIP1/WAF1)) in human cancer cells. British journal of pharmacology. 171(13):3182-95. 2014.
- Wu DM, Zhang P, Liu RY. Phosphorylation and changes in the distribution of nucleolin promote tumor metastasis via the PI3K/Akt pathway in colorectal carcinoma. FEBS letters. 588(10):1921-9. 2014.
Related Products / Services
Please note: All products are "FOR RESEARCH USE ONLY AND ARE NOT INTENDED FOR DIAGNOSTIC OR THERAPEUTIC USE"
